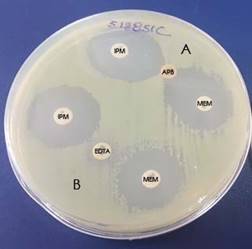

Caso Clínico
Citrobacter freundii multirresistente como agente etiológico de infección de vías urinarias
Multiresistant Citrobacter freundii as an etiological agent of urinary tract infection
Citrobacter freundii multirresistente como agente etiológico de infección de vías urinarias
Kasmera, vol. 47, núm. 1, pp. 09-13, 2019
Universidad del Zulia
Recepción: 24 Septiembre 2018
Aprobación: 11 Enero 2019
Resumen: Citrobacter freundii, en ocasiones puede actuar como patógeno oportunista, se presenta un caso de este microorganismo aislado como agente etiológico de infección del tracto urinario, en un paciente con enfermedad pulmonar obstructiva crónica. El aislado fue multirresistente, mostrando resistencia a gentamicina, amikacina, trimetoprim sulfametoxazole, ciprofloxacino, ceftriaxona, ceftazidima, cefepime, imipenem, meropenem y doripenem y, susceptibilidad a tigeciclina y colistina, el estudio molecular demostró la presencia del gen blaKPC.
Palabras clave: resistencia microbiana a antibióticos, bacteriuria, Citrobacter freundii.
Abstract : Citrobacter freundii, sometimes it can act as opportunistic pathogen, a case of this isolated microorganism is presented as an etiological agent of urinary tract infection, in a patient with chronic obstructive pulmonary disease. The isolate was multiresistant to gentamicin, amikacin, trimetoprim sulfamethoxazole, ciprofloxacin, ceftriaxone, ceftazidime, cefepime, imipenem, meropenem and doripenem and it was susceptible to tigecycline and colistin, the molecular analysis showed the presence of the blaKPC gene
Keywords: drug resistance microbial, bacteriuria, Citrobacter freundii.
Introducción
Citrobacter freundii es un bacilo Gram negativo perteneciente a la familia Enterobacteriaceae, de la tribu Citrobacter. A diferencia de otras especies de Citrobacterias productoras de H2S y de las salmonelas, este microorganismo no es capaz de descarboxilar lisina, hidrolizar ONPG (orto-nitrofenil-ß-D-galactopiranósido) y crecer en caldo de cianuro de potasio (KCN). C. freundii, es causante de infecciones intestinales y extraintestinales como: infecciones del tracto urinario (ITU) y septicemia. Junto con especies de Enterobacter, Klebsiella, Proteus y Serratia, constituyen los patógenos oportunistas más frecuentemente aislados 1-3.
La resistencia antimicrobiana es un problema global que ha hecho que las terapéuticas actuales no solucionen las infecciones bacterianas, dentro de los mecanismos de resistencia actuales más importantes y de gran impacto está la resistencia a los carbapenémicos en Enterobacteriaceae (CRE), suscitado como en la mayoría de los casos, como consecuencia del uso indiscriminado de antibióticos en medicina humana y veterinaria; éstas, son enzimas capaces de hidrolizar a los carbapenémicos y otros β-lactámicos, se destacan: Clase A de Ambler: KPC-2 a 18; Clase B: metalo- β- lactamasas (VIM 1 a 41 e IMP 1 a 48, y las NDM-1 a NDM-12 y Clase C: (detectadas en Acinetobacter spp.) OXA-23, OXA-25 a 27, OXA-40, OXA-51, OXA-55, OXA-58 y OXA-143 4.
En China a través del estudio Epidemiology of Carbapenem-Resistant Enterobacteriaceae infections: Report from China CRE Network, realizado de enero a diciembre de 2015, se reportaron 664 casos de CRE, se demostró que el 73,9 % de los casos fueron causados por K. pneumoniae, seguido de E. coli (16,6%) y E. cloacae (7,1 %) 5.
C. freundii, conocido como agente etiológico de una gran variedad de patologías como ITU, heridas, infecciones gastrointestinales, meningitis y sepsis; especialmente en pacientes inmunocomprometidos y hospitalizados, es también un microorganismo que puede adquirir resistencia a varias clases de antibióticos, como se revela en el estudio hecho por Leski y col 6.
La resistencia desarrollada por C. freundii es reportada desde hace algunos años, en el 2003 Naveen Gupta y col (7) en India, realizaron un estudio de 176 casos de bacteriemia por Citrobacter, el 79,1% de los casos de bacteriemia fueron producidos por C. koseri y el 20,9% por C. freundii. La puerta de entrada identificada más frecuentemente fue la vía respiratoria con un 20,9%; mientras que los tractos gastrointestinal y urinario lo fueron con un 15,3% respectivamente. En cuanto a la resistencia a los antimicrobianos, se determinó que los aislados de C. freundii, fueron más resistentes que los de C. koseri; el 79,1 % de estos aislados fueron multirresistentes.
Se han reportado casos de cepas de C. freundii con este tipo de resistencia, en China 8 se aislaron cepas resistentes de muestras de aguas residuales del Wets China Hospital en enero de 2015, se reportó una cepa portadora del gen blaKPC y blaNDM , así mismo, se encontró C. freundii altamente resistente aislado a partir de una muestra de orina en el Mercy Hospital Research Laboratory, en Sierra Leona 6. En estudios realizados en España para determinar la epidemiología molecular de Enterobacterias productoras de carbapenemasas se determinó que, de 20.093 aislados, 47 mostraron baja sensibilidad a los carbapenémicos y 9 fueron productores de carbapenemasas, 4 de ellos fueron identificados como C. freundii; según su origen, 2 fueron aislados de pacientes ambulatorios y 7 de pacientes hospitalizados; el 44,44 % se aisló en urocultivos 5-7.
En el caso clínico estudiado el paciente tenía antecedentes patológicos personales importantes para el desarrollo de infecciones sobreañadidas, presentaba enfermedad pulmonar obstructiva crónica (EPOC), este es un estado en el cual existe limitación del flujo de aire que no es del todo reversible, cuya prevalencia en el 2016 fue de 251 millones de casos según la Organización Mundial de la Salud 8, la misma organización indica, “en 2015 murieron por esta causa cerca de 3,17 millones de personas en todo el mundo, representando el 5 % de las todas las muertes de ese año”. En Estados Unidos se ha reportado como la tercera causa de muerte afectando a más de 10 millones de personas 8-13.
Las infecciones respiratorias son causa importante de exacerbaciones de EPOC cuadro por el cual el paciente ingresa a la emergencia de Hospital de referencia a nivel local. El paciente además presenta antecedentes de hospitalización previa, factor que predispone a infecciones de tipo intrahospitalario. El diagnóstico de base, exacerbado por un episodio de neumonía nosocomial que se desarrolla posterior al presente ingreso, sumando a ITU diagnosticada por urocultivo positivo a las 48 horas posteriores al ingreso; hace que se cumplan los criterios que se han mencionado como predisponentes de infección intrahospitalaria causada por un agente multirresistente como C. freundii productor de carbapenemasa.
Historia Clínica
Paciente de sexo masculino de 89 años de edad, con residencia en zona urbana de la ciudad de Loja, estado civil soltero y de ocupación agricultor; antecedentes clínicos de importancia: hipertensión arterial, hipertrofia prostática benigna y enfermedad pulmonar obstructiva crónica, (EPOC), es importante destacar que 4 días antes al presente ingreso el paciente estuvo hospitalizado con diagnóstico de pancreatitis aguda y EPOC, es ingresado a Hospital Provincial “Isidro Ayora” de la misma ciudad; por cuadro clínico de alza térmica no cuantificada de 12 horas de evolución y astenia, el diagnóstico de ingreso: Neumonía nosocomial e Injuria Pulmonar Aguda
El examen físico de ingreso revela. TA: 100-63 mmHg, FC: 78 lpm; FR. 26 rpm, SatO2: 86% con FiO2 del 28%, Glasgow: 14/15. Paciente cianótico. Zona peribucal cianótica. Tórax: corazón rítmico. Pulmones: murmullo vesicular disminuido en ambos campos pulmonares y abolido en base pulmonar izquierda. A la auscultación: ruidos crepitantes y sibilancias en ambos campos pulmonares. Se solicitan exámenes de laboratorio: Biometría hemática, glucosa, urea, creatinina, proteína C reactiva, elemental y microscópico de orina y se toman muestras para realizar hemocultivo, urocultivo y baciloscopía.
Al momento del ingreso se inicia tratamiento farmacológico con: piperacilina+tazobactam 3,5 gr. cada 6 horas por vía endovenosa, azitromicina 1 gr. por vía oral cada 24 horas, nebulizaciones con salbutamol cada 8 horas, hidrocortisona 100 mg. cada 8 horas por vía intravenosa y antipiréticos. Con los resultados de los exámenes, el diagnóstico de ingreso a hospitalización es de EPOC reagudizada más infección del tracto urinario (ITU).
Al segundo día de hospitalización se cambia el tratamiento antibiótico por meropenem 1 gr. intravenoso cada 8 horas y se agrega acetilcisteína 300 mgr. intravenoso cada 8 horas. Durante la hospitalización el paciente presenta complicaciones pulmonares: Derrame pleural masivo derecho, se realiza toracocentesis en dos ocasiones la última guiada con ecografía obteniéndose 1000 mL de líquido serohemático que, al examen citológico y bioquímico es compatible con exudado, el examen bacteriológico resulta negativo. Los exámenes de control posterior a la terapia instaurada demostraron mejoría; biometría hemática y química sanguínea dentro de parámetros normales. Luego de 25 días es dado de alta con importante mejoría clínica.
Resultados de Laboratorio
Los resultados de laboratorio solicitados al ingreso del paciente en emergencia fueron biometría hemática: Leucocitos: 11,3x106 cel/mm3, fórmula diferencial (valores relativos): Neutrófilos. 67,6%, Linfocitos: 22,7%. Glucosa: 117 mg/dL; urea: 66,7 mg/dL, Creatinina: 1,7 mg/dL; PCR: 2,8 mg/dL; Examen elemental y microscópico de orina: Leucocitos: campo lleno; Eritrocitos: 4-6/c; Bacterias: +++, hemocultivo y baciloscopía negativa; el urocultivo resultó positivo y la identificación y pruebas de susceptibilidad del microorganismo aislado se realizaron mediante el equipo Vitek 2 de Biomerieux® identificándolo como Citrobacter freundii, resistente a cefalosporinas y carbapenémicos con concentraciones mínimas inhibitorias para ceftazidima ≥ 16 μg/mL; ceftriaxona y cefepime ≥ 64 μg/mL; imipenem y meropenem ≥16 μg/mL; doripenem 4 μg/mL; sensible a amikacina y gentamicina con CIM 8 y 4 μg/mL respectivamente; intermedio para ciprofloxacino CIM de 2 μg/mL y sensible a tigeciclina y colistina con CIM de 0,5 μg/mL respectivamente; en un segundo urocultivo realizado dos días después de hospitalización se notó evolución a resistencia para gentamicina, amikacina y ciprofloxacino. Se realizó la prueba fenotípica de búsqueda de carbapenemasas según los criterios de la Tabla Nº 3C del CLSI M100-S28 12, obteniéndose inactivación del carbapenémico positiva; se realizó la prueba de sinergia de discos y se obtuvo reacción positiva entre ácido fenilborónico e imipenem; se realizó la prueba con discos combinados obteniéndose una diferencia de 7 mm entre el disco de meropenem y meropenem/borónico, resultados compatibles para la producción de una serinbetalactamasa KPC (Figura 1), se utilizaron como controles de calidad internos positivo a K. pneumoniae BAA-1705 y negativo a K. pneumoniae BAA-1706. La cepa fue confirmada molecularmente por reacción en cadena de polimerasa convencional en los laboratorios del Instituto Nacional de Investigación en Salud Pública del Ecuador identificándose blaKPC.
Discusión
La resistencia a los antimicrobianos es actualmente un problema de salud pública de preocupación mundial, la producción de carbapenemasas es un mecanismo diseminado en Enterobacteriaceae, que les confiere resistencia a todos los betalactámicos incluyendo los carbapenémicos, aspecto que representa un reto para los clínicos por las pocas opciones terapéuticas para el tratamiento, tal como se observa en la cepa reportada en este caso, cuyas opciones de tratamiento serían tigeciclina y colistina; por lo que la comprensión de este mecanismo de resistencia y su comportamiento epidemiológico en las infecciones ayudarán al control de su diseminación 6,14-15.
Citrobacter freundii es una bacteria Gram negativa que pertenece a la familia Enterobacteriaceae, está presente en el ambiente y en la microbiota del intestino del ser humano; es frecuente patógeno de infecciones asociadas a la atención de salud del tracto respiratorio, tracto urinario y sangre, la resistencia a múltiples familias de antibióticos se reporta cuando actúa como agente oportunista en pacientes inmunocomprometidos, en el presente caso se aisló C. freundii blaKPC de un paciente con hospitalizaciones previas y comorbilidades lo que sugiere su papel como oportunista, esto puede explicarse debido a la posible colonización que ya se reporta en otros estudios como un problema emergente por la presencia de Citrobacter freundii blaKPC-3 en pacientes hospitalizados identificados al realizar el hisopado rectal para detectar CRE, concluyendo que es conveniente ejecutar programas de vigilancia activos que permitan tanto la detección de CRE como para el control de su diseminación y propagación 16-18.
C. freundii resistente a carbapenémicos se ha reportado como agente etiológico de infección de vías urinarias en varios estudios considerándose endémico en China, donde se encuentra en la comunidad y, en otros estudios se asocian al cuidado de la salud en infecciones de tracto urinario; este microorganismo produce la cefalosporinasa AmpC a nivel cromosomal gracias al gen blaCMY-79 y, un plásmido grande estructuralmente idéntico al reportado en Klebsiella pneumoniae que contiene los genes aac(3)-III, blaTEM-1, blaCTX-M-15, lo que le permite ser calificado como un reservorio de determinantes de resistencia a los antimicrobianos explicando entonces la multirresistencia a aminoglucósidos, fluoroquinolonas, sulfamidas y betalactámicos tal como ocurre con la cepa productora de KPC de este caso; de forma que si bien es cierto E. coli es el agente etiológico más frecuente en infecciones del tracto urinario no se debe descartar la presencia de bacterias oportunistas multirresistentes 6,14,19-22.
Citrobacter freundii es una bacteria capaz de desarrollar multirresistencia gracias a la presencia de genes que le permiten producir enzimas como la KPC, en este caso su tratamiento se complica porque las opciones terapéuticas se restringen a tigeciclina y colistina, actúa como oportunista y puede colonizar a personas en comunidad por lo que su diseminación debería ser controlada.
Agradecimientos:
Al Hospital Isidro Ayora, por permitir realizar la investigación y al Instituto Nacional de Investigación en Salud Pública del Ecuador en particular al Centro de referencia Nacional de Resistencia a los antimicrobianos, por su colaboración en el control de calidad y confirmación de cepas aisladas
Referencias Bibliográficas
1. Procop G, Church D, Hall G, Janda W, Koneman E, Schreckenberger P, et al. Koneman Diagnóstico Microbiológico. Texto y Atlas. 7 Ed. Mendoza C, Karen E, editores. Barcelona: Kluwer, Wolters; 2018. p 267-269.
2. Brooks G, Carroll K, Butel J, Morse S, Mietzner T, Jawets M. Jawetz, Melnick y Adelberg. Microbiología Médica. 25 Ed. Mexico DF: McGrawHill; 2010. p 213-216.
3. Forbes B, Sahm D, Weissfeld A. Bailey & Scott Diagnóstico Microbiológico. 12 Ed. Buenos Aires: Editorial Médica Panamericana; 2009. p 328-330 .
4. Vignoli R. Manual de Mecanismos de Resistencia a Antibióticos Macrólidos y Lincosaminas. 2016;. p. 1-14. Disponible en: https://docplayer.es/42315500-Manual-de-mecanismos-de-resistencia-a-antibioticos.html
5. Zhang Y, Wang Q, Yin Y, Chen H, Jin L, Gu B, et al. Epidemiology of carbapenem-resistant Enterobacteriaceae infections: Report from the China CRE Network. Antimicrob Agents Chemother. 2018;62(2); e01225-16. Disponible en: https://aac.asm.org/content/62/2/e01882-17
6. Leski TA, Taitt CR, Bangura U, Ansumana R, Stenger DA, Wang Z, et al. Finished Genome Sequence of the Highly Multidrug-Resistant Human Urine Isolate Citrobacter freundii Strain SL151. Genome Announc. 2016;4(6):e01225-16. Disponible en: http://genomea.asm.org/lookup/doi/10.1128/genomeA. 01225-16
7. Gupta N, Yadav A, Choudhary U, Arora DR. Citrobacter bacteremia in a tertiary care hospital. Scand J Infect Dis. 2003;35(10):765-8. Disponible en: https://doi.org/10.1080/00365540310016376
8. Organización Mundial de la Salud. Enfermedad pulmonar obstructiva crónica (EPOC). WHO. World Health Organization; 2013 [citado 17 de diciembre de 2018]. Disponible en: Disponible en: https://www.who.int/respiratory/copd/es/
9. Wu W, Espedido B, Feng Y, Zong Z. Citrobacter freundii carrying blaKPC-2and blaNDM-1: Characterization by whole genome sequencing. Sci Rep. 2016;6:30670. Disponible en: https://doi.org/10.1038/srep 30670
10. Bueno Sancho J, Seral García CP, Castillo García FJ. Epidemiología molecular de enterobacterias productoras de carbapenemasas. Trabajo fin de Master Iniciación a la Investigación en Medicina. Universidad de Zaragoza; 2015. Disponible en: https://zaguan.unizar.es/record/47451/files/TAZ-TFM-2015-161.pdf
11. Reilly J, Silverman E, Shapiro S. Enfermedad pulmonar obstructiva crónica. En: Longo D, Fauci A, Kasper D, Stephen H, Lameson JL, Loscalzo J, editores. Harrison Principios de Medicina Interna. 18 Ed. Volumen 2. Mexico D.F. McGraw-Hill Interamericana Editores, S.A. de C.V.; 2012. p 2151-2.
12. CLSI. Performance Standards for Antimicrobial Susceptibility Testing. 28th Ed. Wayne PA. Clinical and Laboratory Standards Institute-CLSI. 2018 p 296.
13. Kalpana G, Trautner B. Infecciones de vías urinarias, pielonefritis y prostatitis. En: Longo D, Fauci A, Kasper D, Stephen H, Lameson JL, Loscalzo J, editores. Harrison Principios de Medicina Interna . 18 Ed. Volumen 2. Mexico D.F. McGraw-Hill Interamericana Editores, S.A. de C.V. 2012. p 2387-8.
14. Organización Mundial de la Salud. Enfermedades respiratorias crónicas. WHO. 2016 [citado 14 de agosto de 2018]. Disponible en: Disponible en: https://www.who.int/respiratory/es/
15. Erkens-Hulshof S, Virginia-Cova L, van Dijk W, Severin J, Woodford N, Melchers W, et al. The occurrence of Enterobacteriaceae producing KPC carbapenemases in a general hospital in Curacao. Antimicrob Resist Infect Control. 2014;3(1):24. DOI: https://doi.org/10.1186/2047-2994-3-24
16. Lorenzoni VV, Silva D da C, Rampelotto RF, Brites PC, Villa B, Hörner R. Evaluation of carbapenem-resistant Enterobacteriaceae in a tertiary-level reference hospital in Rio Grande do Sul, Brazil. Rev Soc Bras Med Trop. 2017;50(5):685-8. Disponible en: http://www.scielo.br/scielo .php?script=sci_arttext&pid=S0037-86822017000500685&lng= en&tlng=en
17. Yang L, Li P, Liang B, Hu X, Li J, Xie J, et al. Multidrug-resistant Citrobacter freundii ST139 co-producing NDM-1 and CMY-152 from China. Sci Rep. 2018;8(1):10653. Disponible en: https://doi.org/10.1038/s41598-018-28879-9
18. Venditti C, Fortini D, Villa L, Vulcano A, D’Arezzo S, Capone A, et al. Circulation of blaKPC-3-carrying IncX3 plasmids among Citrobacter freundii isolates in an Italian Hospital. Antimicrob Agents Chemother. 2017;61(8):e00505-17. Disponible en: https://aac.asm.org/content/61/8/e00505-17
19. Gaibani P, Ambretti S, Farruggia P, Bua G, Berlingeri A, Tamburini MV, et al. Outbreak Of Citrobacter freundii carrying Vim-1 in an italian hospital, identified during the carbapenemases screening actions. Int J Infect Dis. 2013;17(9):e714-7. DOI: https://doi.org/10.1016/j.ijid.2013.02.007
20. Gross C, Allen-Bridson K, Anttila A, Brooks JE, Hebden JN, Leaptrot D, et al. Health Care-Associated Infections Studies Project Case #1: A 2015 American Journal of Infection Control and National Healthcare Safety Network data quality collaboration. Am J Infect Control. 2015;43(9):987-8. Disponible en: https://www.ncbi.nlm.nih.gov/pubmed/ 26209338
21. Mahmoud A. M, Tarig M.S. A, Osama M. S, Mariam M. A. Prevalence and antimicrobial resistance pattern of bacterial strains isolated from patients with urinary tract infection in Messalata Central Hospital, Libya. Asian Pac J Trop Med. 2016;9(8):771-6. Disponible en: http://www.embase.com/search/results?subaction=viewrecord&from=export&id=L613140529%0Ahttp://dx.doi.org/10.1016/j.apjtm.2016.06.011%0Ahttp://iacs.c17.net/openurl?sid=EMBASE&issn=19957645&id=doi:10.1016%2Fj.apjtm.2016.06.011&atitle=Prevalence+and+antimicro
22. Hazen TH, Mettus RT, McElheny CL, Bowler SL, Doi Y, Rasko DA. Draft Genome Sequences of blaKPC-Containing Enterobacter aerogenes, Citrobacter freundii, and Citrobacter koseri Strains. Microbiol Resour Announc. 2018;6(8). Disponible en: https://mra.asm.org/content /6/8/e00035-18
Notas de autor
Autor de Correspondencia: Ullauri-González, Carmen https://orcid.org/ 0000-0002-8555-7996. Cátedra de Microbiología, Carrera de Laboratorio Clínico. Universidad Nacional de Loja. Dirección postal: Av. Manuel Ignacio Monteros s/n. Código postal 110103. Loja-Ecuador. Teléfono 072571379 ext 124/0994792263. E-mail: carmen.ullauri@unl.edu.ec